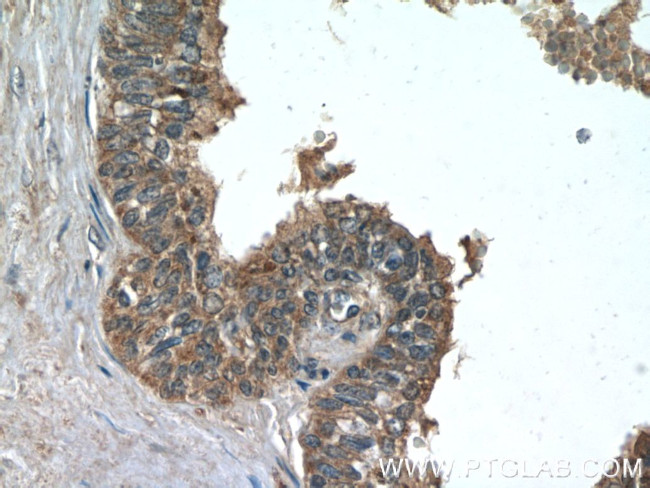
TMEFF2 Antibody in Immunohistochemistry (Paraffin) (IHC (P))

Search
Proteintech
TMEFF2 Polyclonal Antibody
{{$productOrderCtrl.translations['antibody.pdp.commerceCard.promotion.promotions']}}
{{$productOrderCtrl.translations['antibody.pdp.commerceCard.promotion.viewpromo']}}
{{$productOrderCtrl.translations['antibody.pdp.commerceCard.promotion.promocode']}}: {{promo.promoCode}} {{promo.promoTitle}} {{promo.promoDescription}}. {{$productOrderCtrl.translations['antibody.pdp.commerceCard.promotion.learnmore']}}
产品信息
11928-1-AP
种属反应
已发表种属
宿主/亚型
分类
类型
抗原
偶联物
形式
浓度
规格
纯化类型
保存液
内含物
保存条件
运输条件
产品详细信息
Immunogen sequence: MVLWESPRQ CSSWTLCEGF CWLLLLPVML LIVARPVKLA AFPTSLSDCQ TPTGWNCSGY DDRENDLFLC DTNTCKFDGE CLRIGDTVTC VCQFKCNNDY VPVCGSNGES YQNECYLRQA ACKQQSEILV VSEGSCATDA GSGSGDGVHE GSGETSQKET STCDICQFGA ECDEDAEDVW CVCNIDCSQT NFNPLCASDG KSYDNACQIK EASCQKQEKI EVMSLGRCQD NTTTTTKSED GHYARTDYAE NANKLEESAR EHHIPCPEHY NGFCMHGKCE HSINMQEPSC RCDAGYTGQH CEKKDYSVLY VVPGPVRFQY VLIAAVIGTI QIAVICVVVL CITRKCPRSN RIHRQKQNTG HYSSDNTTRA STRLI (1-374 aa encoded by BC008973)
靶标信息
TMEFF2 may be a survival factor for hippocampal and mesencephalic neurons. The shedded form up-regulates cancer cell proliferation, probably by promoting ERK1/2 phosphorylation.
仅用于科研。不用于诊断过程。未经明确授权不得转售。
生物信息学
蛋白别名: cancer/testis antigen family 120, member 2; Hyperplastic polyposis protein 1; TMEFF2; Tomoregulin-2; TR-2; transmembrane protein; transmembrane protein TENB2; Transmembrane protein with EGF-like and two follistatin-like domains; unnamed protein product
基因别名: CT120.2; HPP1; TENB2; TMEFF2; TPEF; TR; TR-2; UNQ178/PRO204
UniProt ID: (Human) Q9UIK5
Entrez Gene ID: (Human) 23671